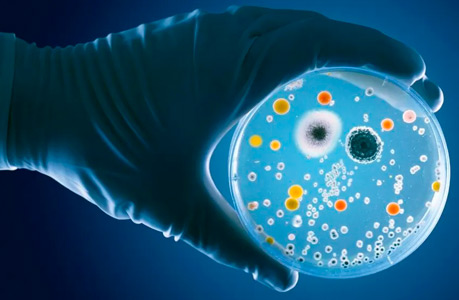

Tu Sistema Inmune revelado a través de
tu ADN.
Conocé más sobre vos y tu sistema inmunológico con nuestro mapeo genético.

Test de Sistema Inmune

El Test de Sistema Inmune te brinda una visión personalizada y profunda de cómo tu ADN influye en tu salud, tu microbiota intestinal y tu respuesta inmunológica.
Gracias a este análisis, es posible identificar predisposiciones a alergias, intolerancias y desequilibrios que pueden afectar tu bienestar a largo plazo.
Devoluciones Online de Test del
"Sistema Inmune"
"Sistema Inmune"
Tu salud, en dos pasos:

Consulta médica + Consulta Nutricional ==> Entendimiento profundo y plan personalizado para tu longevidad.



Contacta con nosotros
Realizá el test de ADN del Sistema Inmune
Conocé cómo tu genética influye en tu salud y obtené un informe personalizado para fortalecer tu bienestar.
Presentes en:
- Argentina 🇦🇷
- Uruguay 🇺🇾
- Estados Unidos 🇺🇸
- España 🇪🇸
Completa el formulario para realizar el test
Cuadro comparativo de nuestros Test de ADN
| 🧪 Test Genético | 🎯 Enfoque Principal | 🌿 Intolerancias y Alergias | ❤️ Salud Cardiometabólica (Diabetes, HTA, Lp(a), ApoB, LDL, HDL) | 💊 Vitaminas (A, B2, B6, B9, C, D) | ☕️ Metabolismo de la Cafeína | 👩⚕️ Consulta Profesional | 💡 Ideal Para |
|---|---|---|---|---|---|---|---|
| Nutricional | Alimentación + metabolismo | Histamina · Lactosa · Celiaquía · Alergias | ✔ | ✔ | ✔ Personaliza energía y metabolismo diario | Médica + Nutricional | Bienestar y control de peso |
| Intolerancia a la Histamina | Intolerancias + alergias | Histamina · Lactosa · Celiaquía | ❌ | ❌ | ✔ Evalúa sensibilidad y reacciones cruzadas con histamina | Nutricional | Diagnóstico de histaminosis |
| Sistema Inmune | Microbiota + defensas | Histamina · Lactosa · Celiaquía | ✔ | ✔ | ✔ Analiza respuesta al estrés, inmunidad y energía | Médica + Nutricional | Refuerzo inmunitario |
| Fertilidad | Metilación + trombofilia + microbiota | Histamina · Lactosa · Celiaquía | ❌ | ✔ | ✔ Evalúa impacto sobre metabolismo energético y hormonal | Médica + Nutricional | Planificación del embarazo y salud ovocitaria |
| Migrañas | Gatillos genéticos + alimentación | Histamina · Lactosa · Celiaquía | ✔ | ✔ | ✔ Determina si la cafeína actúa como disparador o protector | Médica + Nutricional | Identificar disparadores y mejorar calidad de vida |
| Alto Rendimiento | Rendimiento + recuperación | Histamina · Lactosa · Celiaquía | ✔ | ✔ | ✔ | Médica + Nutricional | Deportistas |
| Metilación MTHFR | Folato + homocisteína | ❌ | ❌ | ❌ | ❌ | Sin devolución | Control genético MTHFR |
El Test Sistema Inmune combina el Test Nutricional y múltiples genes que influyen en la composición de tu Microbiota Intestinal.
También determinamos:
¿Cuál es el tipo de alimentación que más te beneficia según tu ADN?.
Necesidades nutricionales
Alergias e intolerancias alimentarias
Factores metabólicos de la salud

La composición de la microbiota intestinal está modulada por múltiples factores, incluidos la forma de nacimiento, la edad, el sexo, la alimentación, las infecciones, el uso de antibioticos/medicamentos, y el genoma de la persona. El genoma humano tiene un rol clave ya que influye en la cantidad y diversidad de las bacterias de la microbiota intestinal.
Los familiares tienen microbiomas intestinales más similares que los no familiares, lo que demuestra la gran importancia del factor genético en su composición. A su vez, una familia presenta microbiomas similares porque en la mayoría de los casos, todos los integrantes se alimentan de una manera similar.
Algunos de los aspectos que se analizan son los siguientes:

?Cómo influyen tus genes en la composición de tu Microbiota Intestinal?
Por otro lado, conocé cómo influyen tus genes en la composición de tu Microbiota Intestinal: La misma está modulada por múltiples factores, incluidos la forma de nacimiento, la edad, el sexo, la alimentación, las infecciones, el uso de antibioticos/medicamentos, y el genoma de la persona. El genoma humano tiene un rol clave ya que influye en la cantidad y diversidad de las bacterias de la microbiota intestinal. Analizamos marcadores genéticos para determinar qué predisposición tenes para desarrollar un disbalance (disbiosis) en tu microbiota intestinal, “permeabilidad intestinal” e inflamación lo que se asocia a un mayor riesgo para desarrollar enfermedades crónicas. Con esta información sumada a la que obtenemos con el test nutricional con nuestro equipo diseñamos un plan de alimentación personalizado con un enfoque anti-inflamatorio.
Conocé ¿qué analizamos en esta parte del estudio?
Niveles de Bifidobacterium en tu microbiota intestinal
Bajos niveles se asocian a un mayor riesgo para desarrollar síndrome metabólico (hipertensión arterial, diabetes, exceso de grasa corporal en la cintura y niveles anormales de colesterol/triglicéridos. Este síndrome aumenta el riesgo de infarto cardíaco y accidente cerebrovascular o ACV).

FUT2: ¿secretor o no-secretor?
Un parámetro de “permeabilidad intestinal” Bajos o altos niveles de Bifidobacterium
Riesgo para desarrollar enfermedades autoinmunes: celiaquía, enfermedad inflamatoria intestinal (colitis ulcerosa y enfermedad de Crohn) y diabetes tipo 1 (juvenil)
Riesgo de infecciones por Candida, urinarias y enfermedades renales Producción de triptófano, fenilalanina y tirosina que son fundamentales en múltiples funciones en nuestro cuerpo, especialmente en el cerebro
Resistente o riesgo de infección por Norovirus que produce la llamada «gastroenteritis de crucero”
Niveles de Anaerostipes, Coprococcus, Roseburia y Lachnospira en tu microbiota intestinal
Los niveles de Anaerostipes, Coprococcus, Roseburia y Lachnospira en tu microbiota intestinal son indicadores clave de un buen equilibrio digestivo. Estas bacterias beneficiosas participan en la producción de ácidos grasos de cadena corta, esenciales para la salud del colon, la modulación del sistema inmunológico y la reducción de la inflamación. Evaluar su presencia permite comprender mejor el estado de tu microbioma y orientar recomendaciones personalizadas para optimizar tu bienestar intestinal.
Riesgo para desarrollar permeabilidad intestinal
El Test de Sistema Inmune mediante saliva permite identificar marcadores asociados al riesgo de desarrollar permeabilidad intestinal, una condición en la que la barrera del intestino se vuelve menos eficiente y permite el paso de toxinas o partículas no deseadas al organismo. Detectar precozmente estas alteraciones ayuda a comprender el impacto sobre el sistema inmunológico y a elaborar estrategias personalizadas para fortalecer la integridad intestinal y mejorar la respuesta inmune.
Riesgo para desarrollar inflamación crónica
A través del análisis de biomarcadores obtenidos en el Test de Sistema Inmune mediante saliva, es posible evaluar el riesgo de inflamación crónica, un proceso silencioso que puede afectar múltiples sistemas del cuerpo y debilitar la función inmunológica. Conocer estos niveles permite anticiparse a desequilibrios que podrían favorecer el desarrollo de enfermedades inflamatorias, orientando intervenciones específicas para modular el sistema inmunitario y promover un estado de salud más equilibrado.
¿Tienes alguno de estos síntomas?
Problemas gastrointestinales
Hinchazón
SIBO
A través de nuestros test genéticos podés acceder a información precisa y personalizada que te permitirá tomar decisiones claras para mejorar tu salud y bienestar.
Da el primer paso hoy y accedé al formulario.
Defensas genéticas, conoce más del Sistema Inmune
El sistema inmune cumple un papel esencial en la protección del cuerpo frente a virus, bacterias y agentes externos. Sin embargo, no todas las personas responden igual ante las infecciones o enfermedades. Muchas veces, detrás de una baja resistencia o de una reacción exagerada del organismo, existen factores genéticos que determinan cómo actúan nuestras defensas. Con el Test del Sistema Inmune, podés conocer en detalle cómo funciona tu inmunidad y qué tan eficiente es tu respuesta ante diferentes estímulos.
En el Centro de Genética Jorge Dotto, ofrecemos un test genético inmunológico mediante muestra de saliva, un método moderno, preciso y totalmente online. Este estudio analiza los genes involucrados en la regulación de la respuesta inmune, permitiendo identificar si existe predisposición a tener defensas bajas, procesos inflamatorios crónicos o una mayor sensibilidad a infecciones. Los resultados se entregan con un distintivo personalizado, acompañado de una devolución profesional para interpretar correctamente cada marcador analizado.

Entender tu inmunidad es el primer paso para cuidarla mejor
A través del test del sistema inmunológico, es posible conocer si tu organismo presenta variaciones genéticas que afectan la producción de citoquinas, la función de los linfocitos o la eficiencia de tu respuesta ante infecciones. Este tipo de análisis es ideal para personas que sufren resfríos frecuentes, alergias, inflamaciones persistentes o simplemente desean fortalecer su salud a nivel preventivo. Además, el estudio puede orientar cambios en la alimentación, el estilo de vida y la suplementación personalizada según tu perfil genético.
El proceso es sencillo y se realiza a distancia: se solicita el kit de muestra de saliva, se envía al laboratorio y en pocos días se obtiene el informe completo online. Cada resultado es analizado por profesionales del Centro de Genética Jorge Dotto, quienes brindan una devolución personalizada y clara para comprender cómo actúa tu sistema inmune y cómo podés fortalecerlo de forma efectiva.
El test genético del sistema inmune es una herramienta innovadora que permite anticiparse a posibles desequilibrios y actuar de manera preventiva. Si querés conocer a fondo cómo funcionan tus defensas, te invitamos a realizar el test de inmunidad online con nuestro equipo rellenando el formulario. Comprender tu genética es el primer paso para cuidar tu salud desde la raíz.
Centro de Genética
Otros Test Disponibles
Descubrí mucho más sobre tu salud y bienestar con nuestros Test Genéticos.
✨ ¡Conocé tu ADN y potenciá tu vida al máximo!
Detectá tu sensibilidad genética a la histamina con nuestro test.
Nuestro Equipo de Expertos
Contamos con un equipo multidisciplinario de profesionales en genética, nutrición y salud, especializados en el desarrollo de test personalizados.
Nuestro objetivo es brindarte información precisa y confiable para que tomes las mejores decisiones sobre tu bienestar.
Centro de Genética Jorge Dotto 2025

Equipo Centro de Genética









